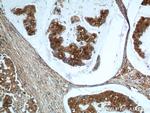
UBC13 Antibody in Immunohistochemistry (Paraffin) (IHC (P))

Search
Proteintech
UBC13 Polyclonal Antibody
{{$productOrderCtrl.translations['antibody.pdp.commerceCard.promotion.promotions']}}
{{$productOrderCtrl.translations['antibody.pdp.commerceCard.promotion.viewpromo']}}
{{$productOrderCtrl.translations['antibody.pdp.commerceCard.promotion.promocode']}}: {{promo.promoCode}} {{promo.promoTitle}} {{promo.promoDescription}}. {{$productOrderCtrl.translations['antibody.pdp.commerceCard.promotion.learnmore']}}
产品信息
10243-1-AP
种属反应
宿主/亚型
分类
类型
抗原
偶联物
形式
浓度
规格
纯化类型
保存液
内含物
保存条件
运输条件
产品详细信息
Immunogen sequence: MAGLPRRII KETQRLLAEP VPGIKAEPDE SNARYFHVVI AGPQDSPFEG GTFKLELFLP EEYPMAAPKV RFMTKIYHPN VDKLGRICLD ILKDKWSPAL QIRTVLLSIQ ALLSAPNPDD PLANDVAEQW KTNEAQAIET ARAWTRLYA (1-148 aa encoded by BC000396 )
靶标信息
The UBE2V1-UBE2N and UBE2V2-UBE2N heterodimers catalyze the synthesis of non-canonical 'Lys-63'-linked polyubiquitin chains. This type of polyubiquitination does not lead to protein degradation by the proteasome. Mediates transcriptional activation of target genes. Plays a role in the control of progress through the cell cycle and differentiation. Plays a role in the error-free DNA repair pathway and contributes to the survival of cells after DNA damage. Acts together with the E3 ligases, HLTF and SHPRH, in the 'Lys-63'-linked poly-ubiquitination of PCNA upon genotoxic stress, which is required for DNA repair. Appears to act together with E3 ligase RNF5 in the 'Lys-63'-linked polyubiquitination of JKAMP thereby regulating JKAMP function by decreasing its association with components of the proteasome and ERAD. Promotes TRIM5 capsid-specific restriction activity and the UBE2V1-UBE2N heterodimer acts in concert with TRIM5 to generate 'Lys-63'-linked polyubiquitin chains which activate the MAP3K7/TAK1 complex which in turn results in the induction and expression of NF-kappa-B and MAPK-responsive inflammatory genes. Together with RNF135 and UB2V1, catalyzes the viral RNA-dependent 'Lys-63'-linked polyubiquitination of RIG-I/DDX58 to activate the downstream signaling pathway that leads to interferon beta production. UBE2V1-UBE2N together with TRAF3IP2 E3 ubiquitin ligase mediate 'Lys-63'-linked polyubiquitination of TRAF6, a component of IL17A-mediated signaling pathway. (Uniprot)
仅用于科研。不用于诊断过程。未经明确授权不得转售。
生物信息学
蛋白别名: bendless protein; bendless-like ubiquitin conjugating enzyme; Bendless-like ubiquitin-conjugating enzyme; E2 ubiquitin-conjugating enzyme N; epididymis secretory protein Li 71; MGC131857; MGC8489; Ubc13; UbcH13; Ubiquitin carrier protein N; ubiquitin conjugating enzyme E2N; Ubiquitin-conjugating enzyme E2 N; ubiquitin-conjugating enzyme E2N (homologous to yeast UBC13); ubiquitin-conjugating enzyme E2N (UBC13 homolog, yeast); Ubiquitin-protein ligase N; yeast UBC13 homolog
基因别名: 1500026J17Rik; AL022654; BB101821; BLU; HEL-S-71; UBC13; UbcH-ben; UbcH13; UBCHBEN; UBCHBEN; UBC13; UBE2N
UniProt ID: (Human) P61088, (Rat) Q9EQX9, (Mouse) P61089
Entrez Gene ID: (Human) 7334, (Rat) 116725, (Mouse) 93765